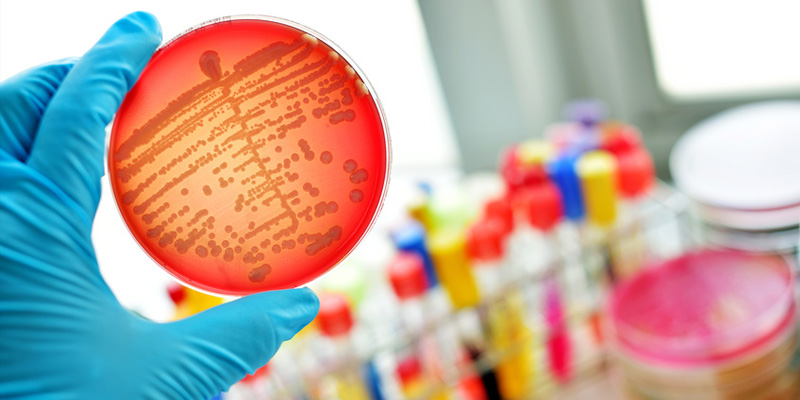
Rheumatisches Fieber

Rheumatisches Fieber – Infektion mit Streptokokken
Das rheumatische Fieber wird auch als Streptokokkenrheumatismus, oder akuter Gelenkrheumatismus genannt. Die Erkrankung tritt nach einer Infektion mit Streptokokken auf, die beispielsweise auch Scharlach, Mittelohrentzündung, oder Mandelentzündung verursachen. In diesen Infektionsfällen kommt es zwischen 0,1 und 3% der Fälle zu einem akutenGelenkrheumatismus. Früher kam diese Form von Rheuma sehr häufig vor, heute ist sie dank moderner Medizin eher selten geworden, zumindest in den Industrieländern. Hier spielen moderne Antibiotika eine herausragende Rolle, die man bereits bei der ursprünglichen Infektion verabreichen kann. Kinder und Jugendliche zwischen 5 und 15 Jahren sind häufiger von der Erkrankung betroffen, als erwachsene Menschen. Charakteristisch für das rheumatische Fieber sind Gelenkentzündungen, die gleichzeitig, oder abwechselnd an mehreren Stellen auftreten. Rasche Diagnosestellung bei Scharlach, Mandelentzündung, oder Mittelohrentzündung, mit entsprechender Therapie mit Antibiotika, können eine Erkrankung an Streptokokkenrheumatismus verhindern. Die Ursache des rheumatischen Fiebers ist noch nicht vollständig geklärt. Vermutet wird allerdings eine Art Überempfindlichkeitsreaktion des Immunsystems, gegenüber bestimmten Streptokokken-Bakterien.
Symptome und Diagnose akuter Gelenkrheumatismus
Wie vorhin erwähnt zählen die wechselnden Gelenkentzündungen zu den häufigsten Symptomen vom rheumatischen Fieber. Des Weiteren können unter der Haut so genannte Rheumaknötchen festgestellt werden. Myokarditis (Herzentzündung) kann ebenfalls auftreten. Bei Mädchen und jungen Frauen kommt es gelegentlich zu Symptomen, die das Nervensystem betreffen. Hier sind die Folgen Bewegungsstörungen. Wie der Name der Krankheit schon sagt, ist für die Erkrankung auch Fieber sehr charakteristisch. Auch dasEKG zeigt Veränderungen, Herzgeräusche treten auf, ebenso starke Gelenkschmerzen. Für die Diagnose ist eine ausführliche Anamnese (Krankengeschichte) erforderlich. Eine Blutuntersuchung wird in jedem Fall durchgeführt. Eine beschleunigte Blutsenkung und die Erhöhung bestimmter Blutwerte können erste Anhaltspunkte liefern. Für die Diagnose müssen bestimmte Kriterien erfüllt sein. Dazu zählen Fieber (um 39-40°C), Blutwerte, die auf eine Streptokokkeninfektion hinweisen, Veränderungen des EKG, Herzgeräusche und/oder Gelenkschmerzen, oder Entzündung des Herzen.
Therapie und Verlauf vom rheumatischen Fieber
Zunächst gilt es festzustellen, ob eine aktuelle Streptokokkeninfektion vorliegt. In diesem Fall erhalten die Patienten hochdosierten Penicillin (alternativ Erythromycin) als Antibiotikum. Die Behandlung mit Antibiotika erfolgt über mehrere Wochen. Gelenkschmerzen werden mit Schmerzmitteln, wie Aspirin, Ibuprofen, Etofenamat, oder Indometacin gelindert. Wichtig ist rasch festzustellen, ob das Herz ebenfalls an der Erkrankung beteiligt ist. Hier ist die Gabe von Cortisonpräparaten das Mittel der Wahl. Ist das rheumatische Fieber in seinem akuten Stadium kann Bettruhe – vor allem bei Herzbeteiligung – verordnet werden. Allgemein gilt hier, die Gelenke zu schonen. Kälteanwendungen sollen hier Beschwerden lindern.
Der Verlauf der Erkrankung kann sehr unterschiedlich ausfallen. Während Erwachsene meist nur über einen milden Verlauf berichten, können die Beschwerden bei Kindern und Jugendlichen stärker sein. Bei Erwachsenen treten in der Regel Gelenkentzündungen auf, begleitet von Rötungen, starken Schmerzen und Schwellungen. Vor allem – in etwa 80% der Fälle – bei Kindern kann zu den Beschwerden auch eine Entzündung der Herzinnenhaut hinzukommen. Bei Herzbeteiligung können auch die Herzklappen und das Herzbeutel entzündliche Reaktionen zeigen. Es gibt Fälle, wo ein rheumatisches Fieber ausschließlich Entzündungen des Herzens verursacht. Häufig steht hier Myokarditis mit Herzschmerzen und Herzschwäche im Vordergrund.
Die Herzbeteiligung zählt zu den schwersten Komplikationen bei dieser Erkrankung. Wird die Erkrankung nicht ausreichend behandelt, kann es zu bleibenden Schäden am Herzen kommen. Zum Vergleich hierzu: Die im Zuge eines rheumatischen Fiebers auftretenden Gelenkschmerzen können auch ohne Behandlung nach einiger Zeit praktisch von alleine wieder verschwinden. Rheumatischem Fieber kann man gezielt wohl nicht vorbeugen. Allerdings kann man Schadensbegrenzung üben. Nach einer Mandelentzündung sollten nach Möglichkeit die Mandeln chirurgisch entfernt werden. Während man der Erkrankung nicht gezielt vorbeugen kann, kann man Rückfälle verhindern, indem man den Patienten über Jahre hinweg Antibiotika verabreicht. Hier liegt allerdings die Dosierung etwas niedriger, als bei einer akuten Bakterieninfektion. Um eventuellen Infektionen vorzubeugen sollte man alle Erkrankungen im Nasen-Rachen-Raum ärztlich untersuchen lassen, insbesondere die, die von Fieber begleitet sind.
Autoren & Experte: Wissenschaftlicher Beirat: Prof. Dr. med. Hermann Eichstädt, Berlin. Facharzt Innere Medizin & Kardiologie, Lebenszeitprofessor i.R. der Charité Berlin. Geschäftsführender Vorstand der Berlin- brandenburgischen Gesellschaft für Herz- und Kreislauferkrankungen e.V. Journalist: Horst K. Berghäuser Heilpraktiker: Felix Teske Literatur, Quellen und Verweise: Rationelle Diagnostik und Therapie in der Inneren Medizin Thieme Verlag Praktische Labordiagnostik - Lehrbuch zur Laboratoriumsmedizin, klinischen Chemie und Hämatologie Grönemeyers Buch der Gesundheit Hallesche Krankenversicherung